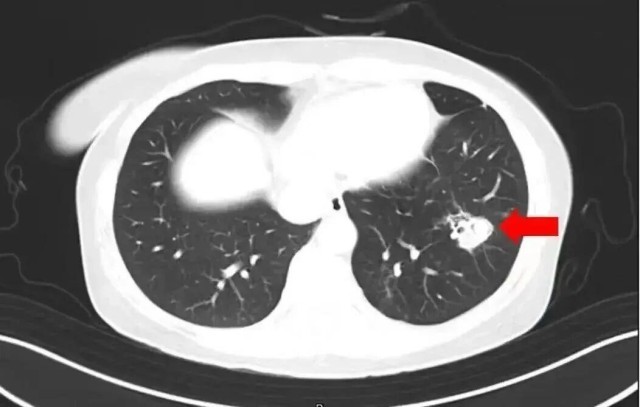

清扫老房子后女孩脑部感染 春节大扫除这些健康隐患要避开
发稿时间:2026-02-12 09:35:00 来源: 央视新闻
近日,有一条新闻引发网友关注:河南郑州一名6岁女孩跟随家人对老家房子进行清扫,随后就开始持续发烧。经医院检查,发现其脑部被真菌侵蚀出很多个“空洞”。罪魁祸首,就是老房子里霉变粉尘中的“烟曲霉”。

“烟曲霉”到底是什么?有何危害?临近春节“掸尘扫房”时,如何杜绝健康隐患?
“烟曲霉”是什么?通常在哪些环境中滋生?
烟曲霉是曲霉菌的一种,曲霉又是一类广泛存在于自然界的丝状真菌。
在我国曲霉菌感染中,烟曲霉感染最多见,其次为黄曲霉、黑曲霉、土曲霉等。烟曲霉菌常隐藏在大家不注意的角落,比如墙角、厨房水池灶台、冰箱内部、洗衣机内部、空调、长时间不用的书籍和地毯等地方。
大部分人机体免疫功能正常,身体会自动把霉菌清除。只有当霉菌数量过多,且人的抵抗力较差时,才容易感染,并非接触霉菌就会感染。
类似事件并非个例。
2025年4月,浙江杭州一女子整理衣柜后出现发烧、咳嗽的症状,体温最高达40℃。医生问诊得知,该女子整理衣柜时发现柜内长了霉斑,便动手清理,但清理过程中没戴口罩。经检查,最终确诊其感染曲霉菌。
2025年1月,江苏扬州的张大爷为迎接春节开始大扫除,清扫过程中不慎吸入大量灰尘和霉菌孢子,导致哮喘发作。张大爷随即服用了常备的哮喘治疗药物,可症状反而逐渐加重。经检查,张大爷的肺部出现感染,确诊为肺曲霉病。
北京佑安医院感染综合科主任医师李侗曾介绍,对于免疫力低下的人,吸入了这些真菌,就会发病引起肺部的病变——曲霉肺炎。因为它是通过呼吸道感染的,进入血液后是可以扩散到全身。大脑因为血供最丰富,所以也是真菌最容易侵犯的器官。
可别小瞧!很多疾病由霉菌引起
家里出现霉点不仅影响美观,还对人体呼吸系统、皮肤、肠道等有潜在威胁。有的霉菌甚至有潜在致癌风险,比如黄曲霉菌能分泌黄曲霉毒素,是一类致癌物。
侵袭呼吸系统
黑曲霉多附着在潮湿的淋浴间及洗漱台周围,容易侵袭孩子、老人或免疫力较弱的人群,诱发呼吸系统疾病和肺病;瓜枝孢多附着在墙面,或浮在空气中,易引发哮喘和呼吸系统疾病。
烟曲霉等特定霉菌,对免疫力较弱的人,还可能带来致命的肺部感染。烟曲霉被世界卫生组织列入首份真菌“重点病原体”清单,侵袭性曲霉菌病一旦发生就是危重症。腐烂的落叶上很可能就附着了烟曲霉。
诱发过敏
霉菌还是重要的过敏原,它能形成网状的菌丝体,产生大量孢子。霉菌孢子体积小,在空气中容易飞散,有些人会出现眼睛皮肤发红发痒、鼻塞、咳嗽等情况。
北京同仁医院曾对门诊过敏性鼻炎患者统计发现,霉菌是过敏性鼻炎的重要原因之一,且夏季更活跃。
引起胃肠炎
霉菌容易造成感染,比如念珠菌引发的食道炎及胃肠炎等。
家中霉菌如何清理?
霉菌通常可通过高温(水温80℃以上、阳光暴晒等)、按说明书配置84消毒液等方式杀灭。对于墙体发霉,如果霉点不严重,可用抹布直接擦掉,也可用漂白水喷雾(有颜色的墙面慎用);如为墙纸,不能用水擦,要用布浸点酒精抹拭。
需要提醒的是,在进行除霉操作时,最好佩戴手套、口罩,并开窗通风。
春节大扫除,这些要注意
春节大扫除时,很多人都会使用清洁剂。有不少人认为清洁剂各有不同功效,混合使用效果会更好,这其实是一种误解,清洁剂混用有时可能产生有毒气体。
洁厕灵+84消毒液=氯气中毒
氯气是一种有毒且具有强烈刺激性的气体,会使人恶心、呕吐、胸口疼痛和腹泻。
84消毒液+洗衣液=有毒物质
洗衣液和84消毒液混合会发生中和反应,降低清洁效果,甚至产生有毒物质。
洗洁精+洁厕灵=清洁效果减弱
洗洁精是碱性清洁剂;洁厕灵属于酸性清洁剂。二者混合会发生中和反应,导致清洁效果大打折扣。
如何避开清洁剂使用“雷区”?
清扫工作前应佩戴专用手套,避免双手直接接触清洁剂。
戴上口罩,避免清洁剂刺激呼吸道。
戴上护目镜,以防清洁剂溅入眼睛,造成眼部损伤。
避免清洁剂“混搭”使用。